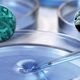
Microstop

-
Redi desmontó la teoría de la generación espontánea y demostró que esto no era así mediante un experimento que realizó en el 1668.
-
Descubrió que en una gota de agua de estanque pululaba una asombrosa variedad de pequeñas criaturas a las que denominó “animálculos”.
-
Describió los hongos filamentosos y descubrió la estructura celular de las plantas, pero el trabajo con microscopios compuestos aplicados al estudio de los “animálculos” languideció durante casi 200 años, debido a sus imperfecciones ópticas.
-
Descubrió la vacuna frente a la viruela
-
Experimentos oficiales en navíos de la marina francesa demostraron la eficacia de las conservas por su método Appert.
-
La primera prueba experimental de un agente biológico como causa de una enfermedad epidémica la proporcionó Agostino Bassi en 1835
-
Propuso y demostró que el uso de cloruro de calcio para la higiene intrahospitalaria del personal sanitario disminuye las tasas de mortalidad
-
Pudo demostrar que los casos de cólera se agrupaban en las zonas donde el agua consumida estaba contaminada con heces fecales
-
Refuto con sus experimentos la teoría de la generación espontánea.
-
Demostró que su metodo de antisepsia reduce la tasa de mortalidad con los resultados relativos a amputaciones en 1970.
-
Publicó la primera clasificación de las bacterias basada en su morfología.
-
descubrió y los agentes causantes de Lepra, el bacilo de Hansen (actualmente Mycobacterium leprae).
-
Descubrimiento, en 1880, del agente causal de la fiebre tifoidea.
-
Presentó por primera vez su teoría de la transmisión de la fiebre amarilla por un vector, pero se abstuvo de indicar que era el mosquito.
-
Descubrió la bacteria causante de la difteria junto a Klebs; por eso también se conoce al Corynebacterium diphteriae como el bacilo de Klebs-Loeffler
-
Descubrimiento de la fagocitosis, la cual constituyó el núcleo de la teoría de la inmunidad celular, de modo que la fagocitosis se consideraba como la base principal del sistema de defensa inmune del organismo, proceso en el que los leucocitos afluyen en masa a bloquear el agente infectante.
-
Junto a Paul Frosch, descubrió que la fiebre Aftosa o Glosopeda estaba causada por un agente que atravesaba filtros bacteriológicos; posteriormente se detectaría que era un virus.
-
Trabajó en el aislamiento de agentes infecciosos y reinfecciones a partir de cultivos puros, experiencias a partir de las cuales estableció los "Postulados de Koch"
Plan projects on a visual timeline
Map milestones, phases, deadlines, and key events in one place so the sequence is easier to see and share. Timetoast is a timeline maker for work, school, research, and stories.